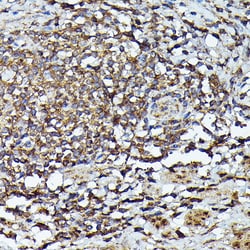
Invitrogen JAK2 Polyclonal Antibody 100 &mu;L; Unconjugated:Antibodies,

Learn More
Invitrogen™ JAK2 Polyclonal Antibody


Rabbit Polyclonal Antibody
Brand: Invitrogen™ PA5120123
Description
Positive test controls include: C6, Mouse brain, Mouse lung. The target is usually found in the following locations: Cytoplasm, Endomembrane system, Nucleus, Peripheral membrane protein. Immunogen sequence: PYGSLRDYLQ KHKERIDHIK LLQYTSQICK GMEYLGTKRY IHRDLATRNI LVENENRVKI GDFGLTKVLP QDKEYYKVKE PGESPIFWYA PESLTESKFS VASDVWSFGV VLYELFTYIE KSKSPPAEFM RMIGNDKQGQ MIVFHLIELL KNNGRLPRPD GCPDEIYMIM TECWNNNVNQ RPSFRDLALR VDQIRDNMAG.
Janus kinase 2 (JAK2) is a protein tyrosine kinase involved in a specific subset of cytokine receptor signaling pathways and is mutated in polycythemia vera. This kinase contains the catalytic domain (JH1) of JAK2. The activation of JAKs can lead to the phosphorylation of STAT (signal transducers and activatiors of transcription) proteins, which dimerize and translocate to the nucleus. Once translocated to the nucleus, the STAT proteins can modify transcription of numerous genes, including interferon-stimulated genes. JAK2 is required for the IFN gamma-receptor complex initiation and JAK1 functions as an amplifier. Some studies have suggested that the role of JAK2 might be performed by Tyk2 and JAK3, if they were positioned correctly within the IFN gamma-receptor complex. Mutations affecting JAK2 can cause Budd-Chiari syndrome, Polycythemia vera, Thrombocythemia 3, myelofibrosis, or Acute myelogenous leukemia.
Specifications
| JAK2 | |
| Polyclonal | |
| Unconjugated | |
| JAK2 | |
| EC 2.7.10.2; Fd17; JAK 2; JAK2; JAK-2; Janus kinase 2; Janus kinase 2 (a protein tyrosine kinase); JTK 10; JTK10; kinase Jak2; THCYT3; Tyrosine-protein kinase JAK2 | |
| Rabbit | |
| Affinity Chromatography | |
| RUO | |
| 16452, 24514, 3717 | |
| -20°C, Avoid Freeze/Thaw Cycles | |
| Liquid |
| ELISA, Immunohistochemistry (Paraffin), Western Blot, Immunocytochemistry | |
| 0.54 mg/mL | |
| PBS with 50% glycerol and 0.02% sodium azide; pH 7.3 | |
| O60674, Q62120, Q62689 | |
| JAK2 | |
| Recombinant fusion protein containing a sequence corresponding to amino acids 933-1132 of human JAK2 (NP_004963.1). | |
| 100 μL | |
| Primary | |
| Human, Mouse, Rat | |
| Antibody | |
| IgG |
Your input is important to us. Please complete this form to provide feedback related to the content on this product.